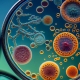
gazi-hastanesi-patoloji-laboratuvari

Manyetik Rezonans Görüntüleme (MR), tıbbi görüntüleme alanında bir devrim niteliğinde olan bir teknolojidir. Bu teknik, vücut içindeki dokuları ayrıntılı olarak görselleştirmek için manyetik alanlar ve radyo dalgaları kullanır. Bu yazıda, Manyetik Rezonans Görüntüleme’nin ne olduğunu, nasıl çalıştığını ve tıbbi alandaki önemini inceleyeceğiz.
MR Tekniğinin Temelleri
Manyetik Rezonans Görüntüleme, vücut içindeki su moleküllerinin manyetik özelliklerini kullanarak görüntü elde eder. Bu teknikte, bir güçlü manyetik alan oluşturulur ve radyo dalgaları gönderilir. Vücuttaki farklı dokular bu dalgaları farklı şekillerde yansıtır ve bu yansımalar bir bilgisayar tarafından detaylı bir görüntüye dönüştürülür.
Kullanım Alanları
Manyetik Rezonans Görüntüleme, birçok tıbbi durumun teşhisinde ve izlenmesinde kullanılır. Beyin, omurga, eklem ve iç organlar gibi birçok bölgenin ayrıntılı görüntülerini sağlar. MR, tümörlerin teşhisi, beyin lezyonlarının değerlendirilmesi, romatizmal hastalıkların izlenmesi ve travma sonrası durumların incelenmesi gibi birçok alanda önemli bir rol oynar.
Avantajları ve Güvenlik
Manyetik Rezonans Görüntüleme, diğer görüntüleme tekniklerine kıyasla birçok avantaja sahiptir. Bu teknik, radyasyon kullanmadığı için güvenlidir ve genellikle yan etkileri yoktur. Ayrıca, MR görüntüleri yüksek çözünürlüklüdür ve yumuşak dokuları detaylı bir şekilde gösterebilir.
Manyetik Rezonans Görüntüleme, tıbbın birçok alanında vazgeçilmez bir araç haline gelmiştir. Bu teknik, vücudun iç dünyasını ayrıntılı bir şekilde keşfetmek ve çeşitli tıbbi durumları değerlendirmek için kritik bir rol oynar. Bu nedenle, MR, modern tıbbın önemli bir parçasıdır ve birçok hastalığın teşhisinde ve tedavisinde hayati bir rol oynamaktadır.